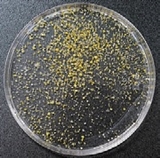
https://cdn.apub.kr/journalsite/sites/ktappi/2020-052-03/N0460520306/images/JKTAPPI_2020_v52n3_58_t001-2.jpg
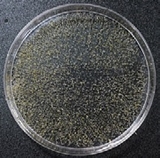
https://cdn.apub.kr/journalsite/sites/ktappi/2020-052-03/N0460520306/images/JKTAPPI_2020_v52n3_58_t001-3.jpg
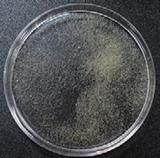
https://cdn.apub.kr/journalsite/sites/ktappi/2020-052-03/N0460520306/images/JKTAPPI_2020_v52n3_58_t001-4.jpg

1. 서 론
귤은 오렌지, 레몬 등을 포함하는 귤속(Citrus)에 속하는 과일로, 국내에서는 주로 제주도 및 일부 남부지방에서 재배되는 주요 과일이다. 2018년 기준으로 국내에서 약 60만 톤 정도가 매년 생산되고 있고, 이 중 30% 이상이 주스 등의 생산을 위한 착즙용 원료로 사용되는데 이러한 착즙 공정에 의해 약 원물의 50% 정도가 착즙 귤박으로 발생한다. 국내의 경우 대체로 매년 약 5-7만 톤의 귤박이 발생되고 있는데, 귤박은 착즙과정 후 세척과정 없이 그대로 배출되기 때문에, 상당량의 귤즙과 귤껍질 등을 포함하고 있다. 이러한 귤박에는 리모넨, 시트르산, 카로테노이드, 바이오플라보노이드, 헤스페리딘, 나린진 등의 다양한 기능성 물질들을 다량 포함되어 있는 것으로 보고되었다.1,2) 특히 귤껍질 부분에 주로 존재하는 리모넨은 항균, 항바이러스, 항염 등의 기능성을 가지는 주요한 기능성 물질로서, 항균제, 화장품, 세제 등 다양한 곳에 사용되고 있다.3) 유기성 폐기물의 해양투기가 금지된 이후로 매년 대량으로 발생되는 귤박의 처리 문제는 주요한 이슈가 되어 왔으며, 귤박의 영양성분 및 기능성 물질을 기반으로 한 사료의 생산4)이나 목질 자원을 대체하는 유기물 원료로서 파티클보드 생산,5) 그리고 활성탄 제조6) 등 다양한 용도로 귤박을 이용하기 위한 노력들이 지속적으로 이루어져 왔다. 그러나 귤박의 소재화를 위한 이러한 방법들의 적용 시 귤박 내에 존재하는 저분자량의 당 성분과 유기물질들로 인해 건조에너지 등 생산비가 많이 요구되고 공정 적용성이 떨어지는 등의 문제로, 대량 발생되는 귤박의 가치 있는 활용에는 적절하지 않아 추가적인 기술개발들이 요구되고 있는 실정이다.
다양한 기능성 물질을 함유한 귤박의 새로운 적용으로 최근 많은 관심의 대상이 되고 있는 친환경 포장 소재의 대체원료를 들 수 있다. 현재 국내외적으로 친환경 포장재의 수요는 지속적으로 증가하고 있는데, 국내의 경우 1-2인 가구 증가, 고령화, 바이러스로 인한 비대면 서비스 수요의 증가 등 다양한 사회생활 형태 변화로 인하여 온라인 위주의 거래가 확대되면서, 온라인에서 구매하는 물품들의 택배 배송에 활용되는 유통포장재의 규모도 꾸준히 증가하고 있다. 유통포장재는 대체로 골판지로 구성되는 박스와 물품의 배송 시 파손을 방지하기 위한 완충재로 구성되는데, 완충재는 주로 1회용 합성수지기반 난분해성 플라스틱 소재가 주로 사용되고 있다. 2018년 이후 중국 등의 폐기물 수입 금지로 인해 폐플라스틱과 같은 난분해성 폐기물 처리 문제가 매년 더욱 심각해지고 있으며,7) 이에 대한 대응을 위하여 국내에서는 2019년 유통포장재 사용 감량을 위한 지침, 재활용 폐기물 관리 종합대책 등 다양한 정책을 수립하고 있지만 근본적으로 기존의 합성수지기반 소재의 활용을 억제할 수 있는 친환경적인 포장 소재의 개발이 절실히 요구되고 있는 실정이다. 이를 위한 대표적인 포장 소재로는 목재펄프 또는 재활용 고지를 주원료로 제조되는 펄프몰드와 같은 고벌크 지류 구조체를 들 수 있다.
특히, 친환경 목재 섬유를 기반으로 제조되는 습식성형 펄프몰드는 고평량 시트상 구조체로, 기존 종이 제품과는 달리 공정 중 강한 압착 탈수 공정을 포함하고 있지 않기 때문에 높은 벌크 특성과 완충성을 가지는 대표적인 친환경 완충 소재이다. 최근 친환경 포장재의 수요 증가로 펄프몰드는 기존 계란, 과일, 기계 부품 등의 완충 포장 소재에서 전자제품, 화장품 등의 고급 제품의 완충재로 활용이 점차 확대되고 있다. 이러한 펄프몰드의 제조 품질과 공정을 개선하고 기능성을 부여하여 그 활용성과 경제성을 증가시키기 위하여 목재 섬유 비율에 의한 제품 특성,8) 다양한 원료 적용,9) 원료에 의한 제품 품질 개선,10) 공정 효율 개선11,12) 등 다양한 연구들이 지속적으로 이루어져 왔다. 하지만 더욱 폭 넓은 적용을 위한 다양한 원료들의 적용과 기능성을 부여하기 위한 연구개발은 아직 미흡한 상황이다.
이에 본 연구에서는 습식 성형되는 펄프몰드 제조 시 폐기성 유기원료인 귤박의 적용을 통해 기능성을 부여하고 생산원가를 절감하기 위한 연구를 진행하였다. 펄프몰드 원료로서의 귤박의 특성을 알아보고 이를 기반으로 적절한 적용을 위한 귤박의 분급과 전처리를 통해 기능성을 가지는 귤박 펄프몰드 제품 제조를 위한 기반자료를 확보하고자 하였다.
2. 재료 및 방법
2.1 공시재료
본 연구에서는 제주에서 감귤의 착즙 공정 후 발생한 귤박을 공급받아 실험재료로 사용하였다. 펄프몰드 시제품 제조를 위한 기본 펄프원료로는 활엽수 표백 크라프트 펄프(hardwood bleached kraft pulp, HwBKP)를 사용하였으며 실험실용 밸리비터(valley beater)로 해리 및 고해하여 CSF 600±5 mL 수준으로 지료를 조성하여 사용하였다.
2.2 귤박 특성 평가
2.2.1 귤박의 용액분 분급 처리
귤박의 활용성 증대를 위한 방안으로 귤박 내의 용액분과 미세분을 200 mesh의 압착스크린을 이용하여 분리하였다. 귤박 원물의 경우 함수율은 80-85%로서 착즙 과정에서 완전히 분리되지 않은 용액 성분이 잔류하고 있었고, 200 mesh 스크린 분리를 실시하는 경우 귤박의 잔류용액과 미세분이 함께 배출되었다. 이렇게 분리된 분급분을 각각 귤박 섬유분과 귤박 용액분으로 지칭하고 이들 각각의 특성을 평가하였다.
2.2.2 귤박의 형태적 특성 평가
귤박의 형태적 특성을 관찰하기 위하여 전자주사현미경(field emission scanning electron microscope, FE SEM, Philips XL30 ESEM TMP, Netherlands)을 이용하였다. 귤박에서 구조적으로 형태를 유지하는 부분들은 대체로 귤껍질에서 유래한 부분들인데 이러한 부분들의 구조적 특성을 본 평가를 통해 확인하였다. 귤박 시료들을 동결시킨 후 횡단면을 절삭하여 초임계 건조기(critical point dryer, CPD 030, Baltec, USA)로 건조 후 내부 미세 구조를 평가하였다.
2.3 귤박 적용 펄프몰드 제조
2.3.1 귤박 원물 적용 펄프몰드 제조
착즙 부산물 귤박 원물을 전처리 없이 펄프몰드 제조공정에 투입하여, 그 영향을 평가하였다. 귤박 원물은 중량 대비 액비를 1:5로 하여 교반기를 이용, 충분히 해리한 후 활엽수 BKP로 이루어진 지료에 무게비 10%로 첨가하여 지료를 조성하고, 습식 펄프몰드 성형기를 이용하여 평량 200±10 g/m2의 조건에서 펄프몰드를 제조하였다. 펄프몰드의 성형 시 진공 압력은 0.04 MPa의 조건에서 성형을 진행하였고, 16 kg의 롤을 이용하여 1회 쿠칭을 실시하였다. 이후 160℃의 열풍건조기를 이용하여 전건하여 펄프몰드 시험편을 제조하였다.
2.3.2 귤박 크기별 분급 및 전처리 귤박 섬유분을 적용한 펄프몰드 제조
귤박 섬유분은 다양한 형태와 크기의 성분들로 이루어져 있는데 이들의 크기별 분급을 실시하여 각각의 형태적 특성을 평가하였다. 이를 위해 귤박 섬유분을 20, 40, 60, 80, 100, 140, 200 mesh의 진동스크린(sieve shaker, Cg-211-8, chunggye sieve corporation, Korea)을 이용하여 각각 분급하였고 각 분급분의 형태적 특성을 평가하였다. 귤박 섬유분 중 40 mesh 이상의 크기를 가지는 섬유분의 경우는 형태적으로 플레이크(flake)와 같은 형태를 가지고 있었기 때문에 실험실용 니더(kneader)로 전처리하여 귤박 섬유분의 크기를 40-200 mesh 사이로 준비하였다. 이렇게 크기별로 형태를 재처리한 귤박 전처리 섬유분을 이용하여 펄프몰드 시험편을 제조하였다. 이때 펄프몰드 시험편의 제조는 2.3.1절의 방법에 준하여 실시하였다.
2.3.3 펄프몰드 제조 시 백수의 탁도 측정 평가
펄프몰드 제조 시 발생하는 백수의 상태를 확인하기 위하여 탁도를 측정하였다. 탁도는 펄프몰드 성형 후 발생하는 백수를 채집하여, 탁도측정기(turbidity meter, TB 210 IR, Lovibond, United Kingdom)를 이용하여 각각의 조건에서 백수 탁도를 측정하였다.
2.3.4 펄프몰드 물리적 특성 평가
제조된 펄프몰드 시험편은 온도 23±1℃, 상대습도 50±2%의 조건에서 최소 24시간 동안 조습처리하였으며, 조습처리 이후 평량은 KS M ISO 536에 의거하여 측정하였고 밀도 및 벌크는 KS M ISO 534에 의거하여 평가하였다.
2.4 귤박 용액분을 활용한 펄프몰드 표면코팅
2.4.1 귤박 용액분 기반 코팅에 제조 및 펄프몰드 표면코팅
귤박 원물로부터 200 mesh 스크린으로 분리한 귤박 용액분과 조대성분의 전처리 과정 중 발생되는 용액성분을 사용하여 펄프몰드 표면 처리용 코팅액을 제조하였다. 흡수성이 높은 펄프몰드의 코팅 처리 효율 증대를 위하여 귤박 용액분을 실험실용 농축기(Rotary evaporator, N-1300, Eyela, Japan)를 이용하여 1, 5, 10, 20 및 30%의 농도로 농축하여 코팅액을 각각 제조하였다. 각 농도별 귤박 용액분을 코팅바를 이용하여 귤박 섬유분이 10% 첨가된 펄프몰드 시험편 표면에 코팅하였고 이후 105℃의 열풍 건조기를 이용하여 2시간 동안 충분히 건조 후 조습처리를 실시한 후 외관 및 향 특성 평가를 진행하였다(Fig. 1).
3. 결과 및 고찰
3.1 귤박의 형태적 특성
3.1.1 귤박 분급분별 형태적 특성 평가
귤박은 귤의 착즙 후 착즙 부산물로 발생하기 때문에 배출되는 귤박은 다양한 크기와 형태를 가지는 무정형의 조대분, 섬유분과 미세분을 가지고 있는 것으로 확인되었다. 귤박의 평균 함수율이 약 80-85% 정도로 착즙 시 완전히 분리되지 않은 주스 성분 및 용해성 성분을 포함한 용액분이 상당량 포함되어 있는 것을 확인할 수 있었다.
귤박 원물을 200 mesh의 압착스크린으로 섬유분과 용액분으로 분급하여 그 각각의 상태를 Fig. 2에 나타내었다. 귤박의 분급 시 용액분의 경우 주스 성분과 미세분을 포함하고 있는 것을 확인할 수 있었다.
3.1.2 귤박 섬유분의 조대성분 구조 특성 평가
귤박 섬유분에 존재하는 조대성분들의 경우 대체로 귤껍질의 조각들로 나타났다. 실제 이러한 귤껍질 부분에는 항균 특성과 향 특성 등을 나타내는 다양한 기능성 물질들이 많이 존재하는 것으로 보고되고 있으며,13,14) 특히 귤껍질에 다량 존재하는 정유 성분 중 무게비로 70-90%는 항균특성을 가지고 있는 것으로 보고된 바 있는 d-limonene 성분으로 보고된 바 있으며,15) 귤껍질 중 오일샘에 이러한 정유성분이 대부분 포함되어 있는 것으로 알려져 있다.16) 귤껍질의 부분들이 귤박 섬유분에 상당량 존재하여 그 형태적 특성을 전자현미경으로 분석하였다. Fig. 3에 나타낸 바와 같이 귤껍질의 내부에 존재하는 오일샘을 확인할 수 있었고 이러한 귤박의 적용을 통해 귤껍질에 포함되어 있는 오일샘을 포함한 기능성 물질들의 용이한 적용이 가능할 수 있을 것으로 판단되었다.
3.2 귤박 적용 펄프몰드 제조 및 특성평가
3.2.1 귤박 원물 적용 펄프몰드 제조 특성 평가
귤박 원물을 10% 적용하여 펄프몰드 시험편을 제조하여 그 외관 상태를 Fig. 4에 나타내었다. 귤박 원물에는 다양한 크기와 형태의 성분들이 포함되어 있어서 이러한 귤박의 구성성분들이 펄프몰드 표면에서 불규칙하게 분포하는 것을 확인할 수 있었다. 특히, 귤박에 포함되어 있는 용액성분들은 펄프몰드 제품의 색상에도 영향을 미칠 뿐만 아니라 펄프몰드 공정 백수에도 큰 영향을 미칠 수 있다. 특히, 습식 펄프몰드 공정에서는 성형탱크에서 백수의 순환이 제한적으로 이루어지기 때문에 이러한 귤박 원료로부터 유입되는 용액 성분들은 몰드 성형 탱크와 성형몰드틀의 심각한 오염을 가져올 수 있을 것으로 판단되었다. 따라서 이러한 과도한 용액 성분의 유입을 막기 위한 귤박 원물의 전처리가 필요한 것으로 판단되었다.
3.2.2 귤박의 전처리와 전처리 귤박의 펄프몰드 적용 특성
3.2.2.1 귤박의 분급 특성과 전처리
귤박 구성분의 크기별 분급 특성을 알아보았다. Table 1에 나타난 바와 같이 20 mesh에 걸리는 조대한 구성성분이 32 wt%로 많은 양을 차지하고 있었고 나머지 200 mesh까지는 총 11 wt% 정도의 분급량을 나타내었다. 200 mesh를 통과하는 용액 및 미세분의 분급량은 약 57 wt%로 귤박 조성에서 매우 높은 비율을 차지하고 있는 것을 확인할 수 있었다.
Table 1.
The morphological properties of each fraction of the citrus pomace depending on the size classification (X: Citrus pomace)
| ① | X >20 mesh (32 wt%) | ![]() | ⑤ | 80 mesh> X >100 mesh | ![]() |
| ② | 20 mesh> X >40 mesh | ![]() | ⑥ | 100 mesh> X >140 mesh | ![]() |
| ③ | 40 mesh> X >60 mesh | ![]() | ⑦ | 140 mesh> X >200 mesh | ![]() |
| ④ | 60 mesh> X >80 mesh | ![]() | ⑧ | 200 mesh> X (Liquid, Fines) (57 wt%) | ![]() |
귤박에서 30% 이상을 차지하는 20 mesh 이상의 조대한 성분들을 그대로 펄프몰드 제조 시 투입하는 경우 앞서 Fig. 4에서 보여지는 것과 같이 불균일한 제품특성이 나타나기 때문에 20 mesh 이상의 조대한 입자를 실험실용 니더로 전처리하여 형태적 특성을 조절하였다. 이후 모든 분급분이 40 mesh를 통과하는 수준까지 전처리를 실시하고 40-200 mesh 분급분의 양을 평가한 결과 41.4 wt%로 확인되었으며, 200 mesh 통과분의 경우 58.6 wt%를 차지하는 것으로 나타났다. 귤박에서 조대한 구성분을 이루고 있는 대부분의 물질은 귤껍질 부분이었는데 니딩 처리에 의해 부스러지는 특성이 나타나면서 미세분의 발생이 많아지고 귤껍질 내부에 존재하는 다양한 기능성 정유 성분 등이 용액 성분으로 빠져나간 영향으로 판단되었다. 본 전처리 과정을 통해 얻어진 200 mesh 통과 용액분의 경우 향후 펄프몰드 코팅용 원료로 활용하였다.
3.2.2.2 전처리 귤박 적용에 따른 펄프몰드 특성 변화
귤박 조대성분의 니딩 전처리를 실시한 이후 분급하여 얻어진 40-200 mesh의 귤박 분급분을 10%, 20% 및 30%씩 각각 펄프몰드에 투입하여 귤박 적용 펄프몰드 시료를 제조하였다. Table 2에서 보여지는 것과 같이 귤박의 투입에 따라 펄프몰드 표면에 황색 섬유분들이 나타나는 것을 확인할 수 있었다. 그러나 기존의 조대한 귤박 성분이 투입되었던 Fig. 4에서의 경우와는 달리 귤박이 상대적으로 균일하게 분포하는 것을 확인할 수 있었다.
Table 2.
The appearance of the pulp mold samples depending on the addition amounts of the citrus pomace
| Addtion amount of the citrus pomace | |||
|---|---|---|---|
| Control (0%) | 10% | 20% | 30% |
![]() | ![]() | ![]() | ![]() |
귤박의 첨가 여부에 의한 펄프몰드 성형 시 백수의 오염도를 알아보기 위해 분급하지 않은 귤박과 용액분을 분급한 귤박을 각각 10% 첨가하여 펄프몰드를 성형하였을 때 성형 후 발생되는 백수의 탁도를 평가하여 Table 3에 나타내었다. 귤박을 첨가하지 않은 경우에서 백수의 탁도는 약 9.8 NTU인 것으로 확인되었다. 용액성분을 제거한 귤박 섬유분을 첨가하여 펄프몰드를 제조하는 경우 백수의 탁도가 약 12.8 NTU로 일정 정도 높아지는 것을 볼 수 있었고, 용액분을 분리하지 않은 경우에서는 백수의 탁도가 약 90.3 NTU로 매우 높아지는 것을 확인할 수 있었다. 이러한 결과들을 통해 펄프몰드 성형 시 귤박 적용하는 경우 성형탱크 백수의 오염심화를 방지하기 위해서는 용액성분의 분리 전처리가 필요한 것을 확인할 수 있었다.
Table 3.
The changes in the turbidity of the white water of the wet pulp mold forming tank with addition of 10% citrus pomace depending on the condition of citrus pomace
| Condition | Turbidity, NTU |
|---|---|
| Control (HwBKP) | 9.8±1.6 |
| Addition of the whole fraction of the citrus pomace | 90.3±5.9 |
| Fiber fractionation of citrus pomace | 12.8±2.1 |
전처리 귤박의 첨가량에 따른 습식 펄프몰드 생산효율 변화를 평가하기 위하여 펄프몰드 성형 직후 각각의 펄프몰드 시료 고형분 함량을 평가하였다(Fig. 5). 귤박의 첨가량이 높아질수록 쿠치에서 고형분 함량이 낮아지는 것을 확인할 수 있었는데 친수성 물질과 상대적으로 미세한 성분들을 많이 포함하고 있는 귤박의 첨가로 인해 펄프몰드 성형 시 탈수성이 저하되는 것으로 판단되었다.

Fig. 5.
Solid contents of wet pulp mold samples at the couch process depending on the addition amounts of the citrus pomace.
귤박의 첨가에 따른 펄프몰드의 구조적 특성변화를 평가하기 위하여 귤박 첨가량에 따른 펄프몰드 벌크 특성 변화를 Fig. 6에 나타내었다. 목재 섬유에 비해 상대적으로 입자상의 미세한 형태를 가지는 귤박의 첨가로 인해 펄프몰드의 벌크는 첨가량이 증가할수록 감소하는 것을 확인할 수 있었다.
귤박의 첨가량에 따른 펄프몰드 제조공정에서의 건조효율 변화를 평가하고자 각각의 첨가량에서 제조된 펄프몰드의 건조속도를 측정하여 Fig. 7에 나타내었다. 귤박 첨가에 의해 펄프몰드의 벌크가 감소하고 귤박에 존재하는 당성분 등의 친수성 물질들의 함량이 증가함에 따라 귤박 첨가량이 증가할수록 건조효율은 지속적으로 감소하는 것을 확인할 수 있었다.
3.3 귤박 용액분의 펄프몰드 표면코팅
귤박 용액분을 농축하여 펄프몰드 표면을 코팅 처리하여 그 영향을 알아보았다. 적용한 펄프몰드 시료는 귤박 섬유분을 10% 첨가하여 적용한 펄프몰드 시료를 사용하였으며 각 농축농도에 따른 표면 특성 변화를 Table 4에 나타내었다. 코팅되는 귤박 용액분의 농도가 높아질수록 펄프몰드의 표면은 진한 귤색을 나타내는 것을 확인할 수 있었다.
Table 4.
The appearance of the coated surface with the citrus pomace liquid fraction depending on the concentration of citrus pomace liquid
| Concentration of citrus pomace liquid fraction | ||
|---|---|---|
| Control | 1% | 5% |
![]() | ![]() | ![]() |
| 10% | 20% | 30% |
![]() | ![]() | ![]() |
귤박 용액분으로 코팅된 펄프몰드의 특성 변화를 알아보기 위하여 적용 코팅액 농도에 따른 귤향 발현 특성을 관능 평가를 통하여 확인하여 보았다. Table 5에서 보여지는 것과 같이 귤박 용액분의 농도를 높여서 적용할수록 강한 귤향이 발생되는 것을 확인할 수 있었는데 이러한 귤향은 귤박 용액분에 포함되어 있는 리모넨과 시트르산 등의 성분에 의한 것으로 귤박 기능성 물질의 적용과 그에 따른 펄프몰드에서 기능성 발현이 가능한 것으로 보여주는 것으로 판단되었다. 귤박의 섬유분이 10% 첨가된 펄프몰드 시료에서는 귤박 용액분의 코팅을 실시하지 않는 경우 귤향이 인지되지 않는 결과로 보아 이러한 귤박 유래 기능성 물질은 귤박 용액분의 직접적 코팅방식으로 적용하는 것이 더욱 효과적인 것으로 판단되었다.
4. 결 론
본 연구에서는 폐기성 귤박의 활용 가치 증대를 위한 방안으로 현재 친환경 포장소재로서 많은 관심의 대상이 되고 있는 펄프몰드 제조 시 대체원료 및 기능성 원료로서의 적용 가능성을 평가하여 보았다. 귤박은 다양한 형태와 크기의 입자들을 포함할 뿐만 아니라 상당량의 용액 성분을 포함하고 있어서 전처리 없이 그대로 펄프몰드의 적용하는 것은 공정오염 및 품질의 저하를 가져올 수 있음을 확인하였다. 귤껍질에서 유래되는 조대한 입자들의 크기조절을 전처리를 실시하고 이를 통해 40-200 mesh 분급분의 섬유분을 펄프몰드 제조 시 첨가하였을 때 펄프몰드의 제조가 가능한 것을 볼 수 있었지만 귤박 섬유분의 첨가량이 증가할수록 성형 시 탈수속도, 건조효율 그리고 벌크가 지속적으로 감소하는 것을 확인할 수 있었다. 귤박 섬유분의 분급과정 중 발생되는 200 mesh 통과 용액분의 경우 농축과정을 거쳐 펄프몰드 표면 코팅액으로 적용할 수 있었는데 이러한 과정을 통해 펄프몰드의 표면에서의 귤향과 귤색의 발현이 뚜렷하게 나타나는 것을 확인할 수 있었다. 추후 귤박 유래 코팅액의 조성과 특성을 강화하는 연구를 통해 귤박의 통합적 활용 가치를 더욱 증가시킬 수 있을 것으로 판단된다.